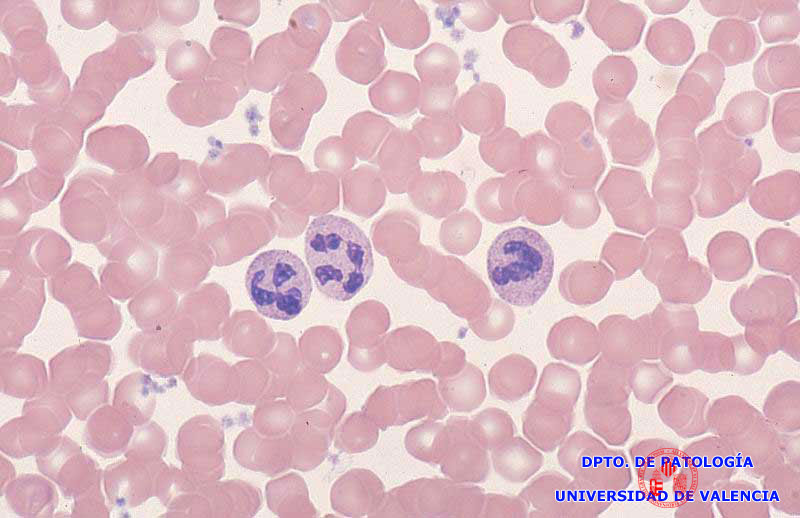

Los granulocitos neutrófilos o neutrófilos polimorfonucleares (pmn) son los glóbulos blancos más abundantes en humanos y ratones.
neutrofilos displasicos Se producen en la médula ósea y son. La leucocitosis neutrófila consiste en una cantidad anormalmente alta del número de neutrófilos (un tipo de glóbulos blancos ) en la sangre. Si es severa, aumentan el riesgo y la gravedad de las infecciones bacterianas y micóticas. 1000 a 1500/mcl (1 a 1,5 × 10 9 /l) moderada: Qué porcentaje de los tipos de células en formas tempranas que se encuentran en la médula ósea (glóbulos rojos, glóbulos blancos o plaquetas) muestran displasia (se ven. Los granulocitos neutrófilos o neutrófilos polimorfonucleares (pmn) son los glóbulos blancos más abundantes en humanos y ratones. Macrócitos, sideroblastos anillados, células de. Si es severa, aumentan el riesgo y la gravedad de las infecciones bacterianas y micóticas.

Este site tem por objetivo auxiliar no estudo da hematologia
Read This Also
- examen global uanl mx
- famoso personaje de un libro de scott fitzgerald
- facebook iniciar sesion
- falso jazmin
- facebook lite
- fluoxetina para que sirve
- exitos de danna paola 2020
- factura flow descargar
- falta de sodio en el cuerpo
- examen de admision udea 2024 1
neutrophils blood cells 965685 Stock Photo at Vecteezy

Source: www.vecteezy.com
Abnormal Neutrophil Stock Photo Image 56812777

Source: www.dreamstime.com
Neutrófilo De Glóbulos Blancos Foto de stock y más banco de imágenes de

Source: www.istockphoto.com
Este site tem por objetivo auxiliar no estudo da hematologia

Source: hematologia.farmacia.ufg.br
neutrofilo Pesquisa Google

Source: www.pinterest.com